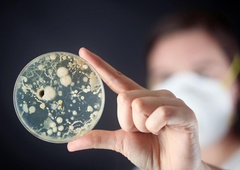
Skrb vzbujajoče: to je predmet, na katerem je več mikrobov kot na straniščni školjki

Vzrok resničnega zdravstvenega stanja ženske je razkril šele kirurški nož.
Znanstveniki so sporočili, da so prvič v zgodovini v človeških možganih našli živega črva. Avstralski zdravniki so povedali, da so lani med operacijo v Canberri Avstralki v čelnem režnju možganov našli živo, osem centimetrov dolgo glisto. Opozorili so, da primer izpostavlja povečano nevarnost prenosa bolezni in okužb z živali na človeka.
“Canberra is a small place, so we sent the worm, which was still alive, straight to the laboratory of a CSIRO scientist who is very experienced with parasites,” Senanayake said. “He just looked at it and said, ‘Oh my goodness, this is Ophidascaris robertsi’.”
— JEME (@ShahenulJeme) August 28, 2023
Ophidascaris… pic.twitter.com/ErspSf09QG
Glista, ki je običajna za avstralske pitone
Ženska je po navedbah zdravnikov trpela zaradi nenavadne kombinacije simptomov - bolečin v trebuhu, kašlja in nočnega potenja, ki so se razvili v vse večjo pozabljivost in depresijo. Dodal je, da bi rdeči parazit lahko bil v njenih možganih do dva meseca.
"Vsi v operacijski dvorani smo doživeli šok, ko je kirurg vzel klešče, da bi odstranil tujek, nato pa se je izkazalo, da gre za živega osem centimetrov dolgega svetlo rdečega črva," je povedala Sanjaya Senanayake, infektologinja bolnišnice v Canberri. Izpostavila je, da tovrstnega primera pri človeku še nikoli niso zabeležili.
Glista Ophidascaris robertsi je običajna za pitone, ki živijo v večjem delu Avstralije. Znanstveniki menijo, da jo je ženska dobila med pobiranjem novozelandske špinače ob jezeru blizu kraja, kjer živi.
🚨: World's first case of live worm found in human brain.
— Policy Scoop (@policyscoop) August 29, 2023
A 64-year-old Australian woman has become the first person in the world to be diagnosed with a brain infection caused by a parasitic worm. The worm, an 8 cm (3.15 inches) roundworm called Ophidascaris robertsi, is… pic.twitter.com/5fseUwbh2g
Vzrok za njene težave razkril šele kirurški nož
Avstralski parazitolog Mehrab Hossain je v reviji Emerging Infectious Diseases zapisal, da sumi, da je ženska postala "naključni gostitelj", ko je za kuhanje uporabila rastline, ki so bile kontaminirane z iztrebki pitona in jajčeci parazita.
Žensko so sprejeli v bolnišnico januarja 2021. Kasneje je slikanje pokazalo "netipično lezijo v desnem čelnem režnju možganov". Vzrok njenega stanja pa je razkril šele kirurški nož med biopsijo junija lani, ki dodaja, da je po operaciji dobro okrevala.
Tudi Hossain je v članku zapisal, da pred tem o vdoru ličink omenjene gliste v možgane niso poročali. Izpostavil je tudi, da je rast ličinke tretjega stadija v človeškem gostitelju pomembna, saj prejšnje eksperimentalne študije niso pokazale razvoja ličink pri domačih živalih, kot so ovce, psi in mačke.
Avustralya'nın başkenti #Canberra'da ameliyatla bir kadının beyninden 8 santimetre uzunluğunda ve 1 milimetre genişliğinde canlı solucan çıkardı. “#Ophidascarisrobertsi” adlı solucanın genelde pitonlarda görülen bir parazit olduğu belirlendi. pic.twitter.com/kHabEwvFyp
— AntalyaBurada.com (@AntalyaBurada) August 28, 2023
Primer je hkrati tudi opozorilo
Infektologinja Senanayake, ki je tudi izredna profesorica medicine na avstralski nacionalni univerzi (ANU), je povedala, da pomeni primer opozorilo. Ekipa univerze je namreč v zadnjih 30 letih ugotovila 30 novih vrst okužb, od katerih so bile tri četrtine nalezljive bolezni, ki so se z živali prenesle na ljudi.
Izpostavila je, da to dokazuje, da se z naraščanjem populacije ljudje vse bolj približujemo in posegamo v habitate živali. "To je problem, ki se pojavlja vedno znova, pa naj gre za virus nipah, ki se je z divjih netopirjev prenesel na domače prašiče in nato na ljudi, ali za koronaviruse, kot sta sars ali mers, ki se je z netopirjev prenesel na drugo žival in nato na ljudi," je izpostavila.